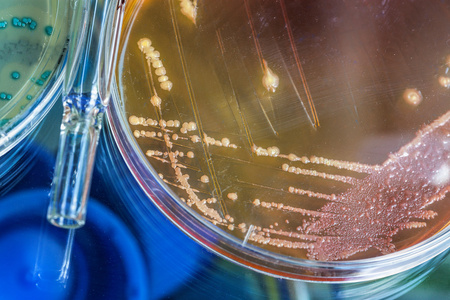
霍乱弧菌试管和培养皿照片

霍乱弧菌培养基

霍乱弧菌显色培养基 1000ml
图片尺寸800x800
tcbs琼脂thiosulfatecitratebilesaltssucroseagarhb4130
图片尺寸741x746
crm009b霍乱弧菌显色培养基平板
图片尺寸412x402
霍乱弧菌的培养基.png
图片尺寸708x693
维生素和生长因子;高含量的氯化钠可促进霍乱弧菌的生长;琼脂是培养基
图片尺寸729x825
弧菌显色培养基
图片尺寸594x595
霍乱弧菌菌落在tcbs上,选择性培养基aga
图片尺寸1200x800
霍乱弧菌检验方法及结果判断
图片尺寸1000x1000
霍乱弧菌的培养基.png
图片尺寸706x381
tcbs--霍乱,副弧,随培养时间的延长霍乱的黄色菌落逐渐变蓝副本
图片尺寸521x480
弧菌显色培养基平板(9cm)
图片尺寸650x650
霍乱双糖铁琼脂质控结果:按标签用法制备培养基,接种以下质控菌株
图片尺寸1527x1156
霍乱弧菌显色培养基使用说明
图片尺寸600x562
tcbs琼脂-霍乱弧菌
图片尺寸600x600
霍乱弧菌1,vibrio cholerae本文由乾界生物蛭弧菌研究室根据tcbs培养
图片尺寸627x425
霍乱弧菌试管和培养皿照片
图片尺寸450x300
麦康凯琼脂使用说明
图片尺寸335x264
现货 用途:用于弧菌的显色培养,副溶血性弧菌显蓝色,霍乱弧菌显红色
图片尺寸280x280
碱基"g"的人群患特定类型的脑瘤风险是携带碱基"a"的人群的6倍以上
图片尺寸839x629
五颜六色的果冻|培养基|琼脂|平板|标本|阴性|弧菌|杆菌|革兰|-健康界
图片尺寸1080x748